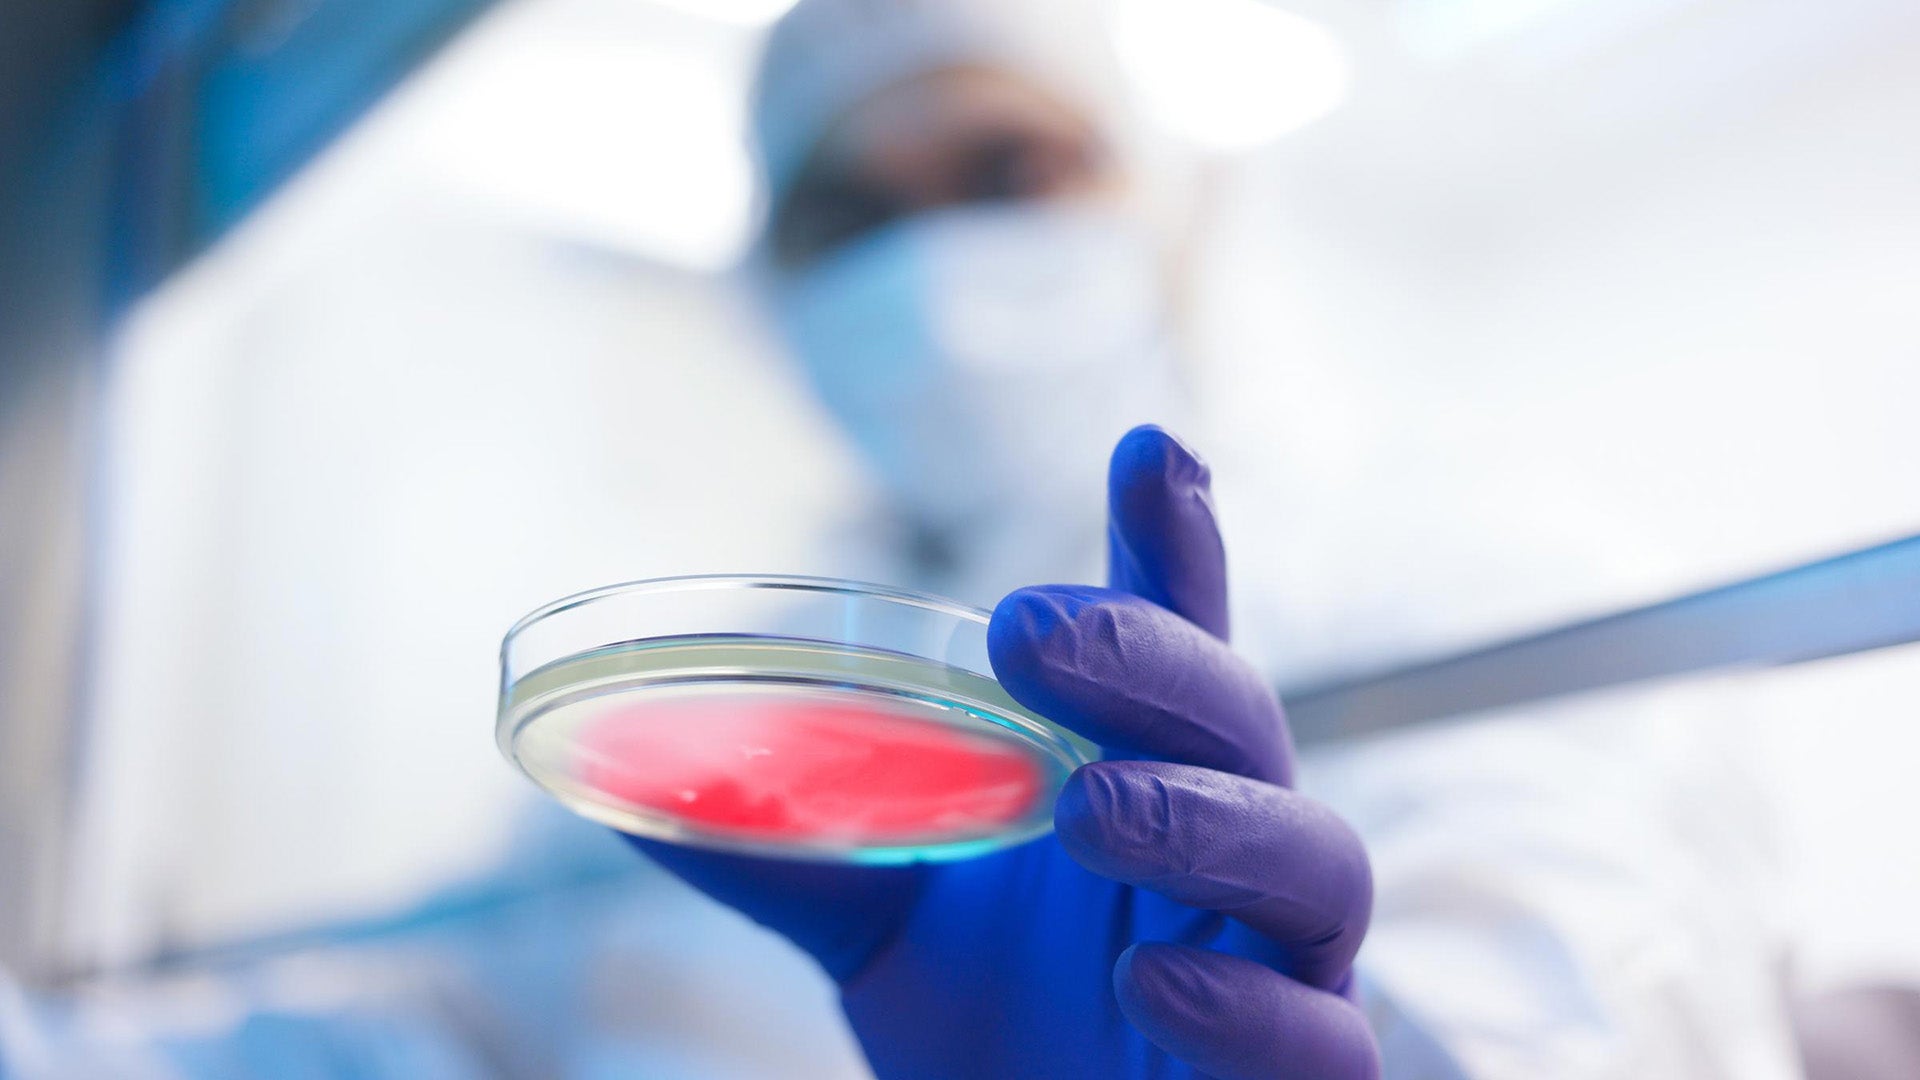

Innovative cardiovascular treatments: Top pharmacotherapy breakthroughs at AHA21
Clarivate experts share takeaways from the 2021 American Heart Association Scientific Sessions (AHA21), with insights on how findings may impact patient care.
As part of our Drugs to Watch™ series, which reviews therapies expected to have significant impact on healthcare markets, Clarivate experts have selected their top picks from the AHA21 Scientific Sessions. This completely virtual meeting presented findings from over 3,600 abstracts. In the following article, we present our analysis of five featured abstracts and our key takeaways for healthcare executives.
1. Empagliflozin shown to be effective for heart failure with preserved ejection traction (HFpEF) of ≥50% in the EMPEROR-Preserved clinical trial1
Despite the multitude of agents approved for heart failure with reduced ejection fraction (HFrEF), demonstrating benefit in patients with HFpEF has proved challenging for drug developers.
Context: In August 2021, Boehringer Ingelheim and Eli Lilly announced that empagliflozin (Jardiance) was the first therapy to show a significant improvement 21% (p<0.001) in outcomes in adults with HFpEF (left ventricular ejection fraction > 40%) in the EMPEROR-Preserved clinical trial.
What’s new from AHA21: In this subanalysis of the EMPEROR-Preserved trial, empagliflozin was shown to be effective in patients with preserved LVEF of ≥ 50% (considered “True HFpEF” by many clinicians, according to the study authors), reducing the risk of the primary endpoint (a composite of CV death or hospitalization for heart failure [HHF]) by 17% (P = 0.0244). This finding was driven by a 22% reduction in the time to first event of a hospitalization for HF (P = 0.0128).
What to expect: These data demonstrate empagliflozin can provide benefits to patients with HFpEF of ≥50%, giving confidence to prescribers that empagliflozin is a strong treatment option for HFpEF patients, including those with True HFpEF. The impact of these data will be determined by how broadly practitioners see the result from EMPEROR-Preserved being applicable to other SGLT-2 inhibitors.
2. EMPULSE demonstrates benefits from empagliflozin in hospitalized heart failure patients2
How could the place of empagliflozin in the treatment paradigm for heart failure change after benefits are seen in the acute setting?
Context: In the past five years we have seen advances in chronic heart failure treatment driven by SGLT-2 inhibitor trials, notably: DAPA-HF, EMPEROR-Preserved, and EMPEROR-Reduced. The SOLOIST trial of Lexicon’s sotagliflozin showed benefit in type 2 diabetes patients recently hospitalized for heart failure. Boehringer Ingelheim and Eli Lilly’s EMPULSE trail of Jardiance (empagliflozin) is the first SGLT-2 inhibitor trial conducted in hospitalized acute heart failure patients, irrespective of diabetes status and ejection fraction status.
What’s new from AHA21: Within the relatively short timeframe of 90 days, patients were 36% (95% CI: 1.09 to 1.68; P = 0.0054) more likely to experience clinical benefit when treated with empagliflozin compared with placebo. The empagliflozin-treated group also reported fewer deaths and heart failure events. EMPULSE adds to the body of evidence that SGLT-2 inhibitors reduce the risk of adverse outcomes in heart failure patients in the acute setting. EMPULSE goes further and specifically demonstrated that SGLT-2 inhibitors should be used in the hospital setting, shifting the timeframe of treatment initiation earlier in the management of the disease.
What to expect: The fact that enrollment was irrespective of type 2 diabetes is another step toward SGLT-2 inhibitors being recognized as cardiovascular treatments in addition to the type 2 diabetes therapies they were originally developed as. The positioning of SGLT-2 inhibitor treatment initiation into the hospital setting will improve the extent to which empagliflozin and perhaps other SGLT-2 inhibitors are used in the long-term management of heart failure patients.
3. Targeted transendocardial delivery of mesenchymal precursor cells reduces the risk of irreversible CV morbidity and mortality in high-risk chronic HFrEF patients with systemic inflammation3
Will Mesoblast’s rexlemestrocel-L (Revascor be the first stem cell therapy to make a meaningful difference in heart failure management?
Context: In December 2020, Mesoblast announced top-line results from the Phase III DREAM-HF trial of its allogeneic cell therapy rexlemestrocel-L in patients with advanced chronic heart failure. Although the primary end point of reducing hospitalizations for heat failure was not met, a significant reduction in the prespecified endpoint of cardiac death was observed.
What’s new from AHA21: A single infusion of rexlemestrocel-L was associated with a 65% reduction in the risk of irreversible morbidity, including non-fatal MI or non-fatal stroke (HR, 0.346; P = 0.001) across all 537 patients, in this new analysis. In the 301 patients with systemic inflammation (baseline plasma high-sensitivity C-reactive protein >2 mg/L) the risk was reduced by 79% (HR, 0.206; 95% CI, 0.070, 0.611; P = 0.004). These benefits were reported for both NYHA class II and III patients but not in those without systemic inflammation. In addition, the time to CV death was significantly reduced by 80% with rexlemestrocel-L in NYHA class II patients with inflammation (HR, 0.204; 95% CI, 0.068, 0.618; P = 0.005).
What to expect: Despite recent advances in treatment options, mortality rates in heart failure remain high. In this trial, the largest to date for a stem cell therapy in heart failure, patients with HFrEF and inflammation have benefited from rexlemestrocel-L. These encouraging findings suggest that rexlemestrocel-L could have a defined place in the heart failure treatment paradigm.
4. First in-human data from MK-0616, an oral PCSK9 inhibitor, shows efficacy for LDL-cholesterol on top of statins4
Although effective, the available drugs targeting PCSK9 are expensive injectable products. An orally administered competitor could be an important new player for hypercholesterolemia and reducing atherosclerotic cardiovascular disease (ASCVD) risk.
Context: Targeting proprotein convertase subtilisin/kexin type 9 (PCSK9) has offered an important advance in terms of additional low-density lipoprotein (LDL)-cholesterol lowering and ASCVD risk reduction on top of primary treatment with statins. However, all currently available (and the most advanced emerging therapies) targeting PCSK9 require injectable administration, which can be a barrier to access, uptake, and compliance.
What’s new from AHA21: Merck presented the first in-human data for MK-0616, an orally bioavailable cyclic peptide targeting PCSK9. In this Phase I multiple-dose study involving 40 participants with elevated LDL-cholesterol levels (85% of whom were receiving moderate or high-intensity statins), MK-0616 was associated with at least a 50% reduction in LDL-cholesterol levels after 14 days. This degree of efficacy is in the range observed for the approved and experimental injectable drugs targeting PCSK9.
What to expect: Many people prefer taking tablets over injections, particularly for conditions needing potentially lifelong treatment like hypercholesterolemia. Although there are numerous orally administered lipid-management products available on the market, many patients remain at high risk for ASCVD events. For such patients, prescribers can turn to Esperion Therapeutics’ oral products, Nexletol (bempedoic acid) and Nexlizet (bempedoic acid plus ezetimibe), or injectable drugs targeting PCSK9, including Amgen’s Repatha (evolocumab), Sanofi / Regeneron Praluent (alirocumab), or the biannually administered Leqvio (inclisiran) from Novartis, which has recently launched in Europe. Treatment cost and compliance are key factors in sustaining effective long-term disease management, a powerful new oral option could be more widely accepted than the injectable competition and rapidly gain traction in the market, especially among primary care physicians.
5. A novel oral factor XIa inhibitor, milvexian, shows promising results for the prevention of venous thromboembolism (VTE)5
Milvexian displayed better efficacy and matching safety compared with current SoC, subcutaneous enoxaparin, following knee arthroplasty. Milvexian has the additional advantage of oral delivery.
Context: Janssen and Bristol Myers Squibb are developing milvexian, which could be a first-in-class oral factor XIa (FXIa) inhibitor. Factor XI amplifies thrombin generation affecting hemostasis, which suggests that targeted FXI inhibition may offer benefits against thromboembolic diseases.
What’s new from AHA21: Data from the Phase II AXIOMATIC-TKR trial of oral milvexian dosed daily from 25 to 400 mg was evaluated in postoperative patients who underwent total knee replacement (TKR) surgery. Daily doses of 100 mg or more considerably reduced the incidence of VTE compared with the standard of care, enoxaparin (7% to 11% vs. 21% respectively), with no increase in bleeding events.
What to expect: Current anticoagulants (older injectables, such as enoxaparin, and newer oral agents, such as rivaroxaban) are used in a variety of settings, including VTE prevention, VTE treatment, and stroke prevention in patients with atrial fibrillation. Despite their importance, their efficacy can be improved and they carry an increased risk of potentially serious bleeding events. Finding the balance between safety and efficacy is critical for anticoagulants; effective novel agents with better risk-benefit profiles could see rapid and wide acceptance among clinicians.
Contributors
Clarivate experts from the Cardiovascular, Metabolic, Renal, and Hematology group who contributed to this article include Yogesh Shelke M.B.A. (Pharm.), Dwaipayan Chatterjee, M.Pharm., Saptaswa Sen, Ph.D., Gideon Heap, M.Sc., David Rees, Ph.D., Tim Blackstock, M.B. Ch.B., and Graeme Green, Ph.D., M.Sc.
Stay on top of the fast-moving cardiovascular landscape and make data-driven decisions.
Access comprehensive market intelligence for hundreds of indications with our Market Assessment Research reports.
References:
- Anker SD, et al. EMPEROR-Preserved: Empagliflozin in Heart Failure with a Preserved Ejection Fraction ≥50% – Results from the EMPEROR-Preserved Clinical Trial. Circulation 2021; 144(suppl1): LBS.05
- EMPULSE: Efficacy and Safety of Empagliflozin in Hospitalized Heart Failure Patients: Main Results from the EMPULSE Trial. Circulation 2021; 144(suppl1):05
- Perin EC, et al. Randomized Trial of Targeted Transendocardial Delivery of Mesenchymal Precursor Cells in High-Risk Chronic Heart Failure Patients With Reduced Ejection Fraction. Circulation 2021; 144(suppl1): LBS.05
- Johns DG, et al. The Clinical Safety, Pharmacokinetics, and LDL-Cholesterol Lowering Efficacy of MK-0616, an Oral PCSK9 Inhibitor. Circulation 2021; 144(suppl1): 06
- AXIOMATIC-TKR: Milvexian for Prevention of Venous Thromboembolism after Elective Knee Arthroplasty: The AXIOMATIC-TKR Study. Circulation 2021; 144(suppl1):07